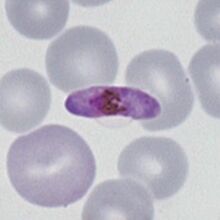

Banana gametocyte: Difference between revisions
From haematologyetc.co.uk
No edit summary |
No edit summary |
||
| Line 9: | Line 9: | ||
<gallery mode="nolines" widths="220px" heights="220px" > | <gallery mode="nolines" widths="220px" heights="220px" > | ||
File:MB1.jpg|: ''P.falciparum'' macrogametocyte|link={{filepath:MB1.jpg}} | File:MB1.jpg|: ''P.falciparum'' macrogametocyte|link={{filepath:MB1.jpg}} | ||
File: | File:MBi2.jpg|: ''P.falciparum microgametocyte''|link={{filepath:MBi2.jpg}} | ||
</gallery> | </gallery> | ||
Revision as of 12:44, 30 March 2024
Navigation
Go Back
| What a "banana" gametocyte?
Additional images
|